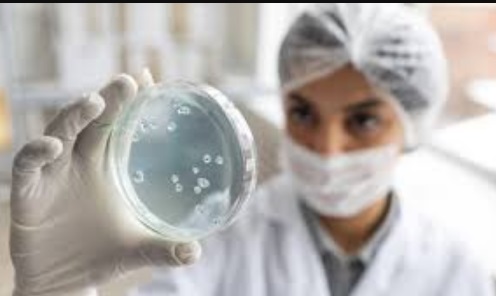

New Delhi: After Prime Minister Narendra Modi warned people against the misuse of antibiotics in his last ‘Mann Ki Baat’ of the year, former Director of AIIMS New Delhi, Dr Randeep Guleria, said if you have any health problem, do not take antibiotics on your own.
“Today, in his ‘Mann Ki Baat’ address, the Prime Minister discussed a significant topic: antimicrobial resistance. Those of us who work in hospitals see that many patients admitted to the hospital, especially those in the ICU, often develop infections for which no antibiotic is effective. They have multidrug-resistant infections, and this is due to antimicrobial or antibiotic resistance…Whenever you have a fever, cough, loose motions, stomach problems, or burning sensation during urination, and you feel that you might need antibiotics, it is crucial to consult your doctor first…I reiterate, if you have any health problem, do not take antibiotics on your own. Consult your doctor and only take them after their advice,” Dr Randeep Guleria said.
NITI Aayog Member (Health) Dr VK Paul said that doctors should ensure that they prescribe antibiotics responsibly and according to the standard protocols.
“In today’s edition of ‘Mann Ki Baat’, the Prime Minister has drawn our attention to the problem of antimicrobial resistance due to the indiscriminate, irrational and unnecessary use of antibiotics…Antibiotics save lakhs and lakhs of lives across the world every year. However, the unscientific and overuse of antibiotics leads to the pathogens becoming resistant to these life-saving drugs.
Studies have shown that many antibiotics are now losing their power against life-threatening infections. The Prime Minister has called upon us to use antibiotics when they are truly needed and only when they are prescribed by doctors. He has strongly cautioned us against self-medication. In this regard, doctors have a special professional responsibility. We, doctors, should ensure that we prescribe antibiotics responsibly and according to the standard protocols…,” Dr VK Paul said.
Referring to a recent report by the Indian Council of Medical Research (ICMR), PM Modi said it has come to light that antibiotics are proving ineffective against many diseases like pneumonia and urinary tract infection. This is a matter of great concern for all of us.
He said the report noted that the “major reason for this is people’s indiscriminate use of antibiotics. Antibiotics are not medicines that should be taken mindlessly. They should be used only on the doctor’s advice. Nowadays, people have started believing that just taking a pill would cure all their problems. This is the reason, diseases and infections are proving to be too strong for these antibiotics.
I urge all of you to refrain from using medicines at your own discretion. This is especially important when it comes to antibiotics. I would simply say: Medicines require guidance, and antibiotics require doctors. This practice will prove to be very helpful in improving your health.”